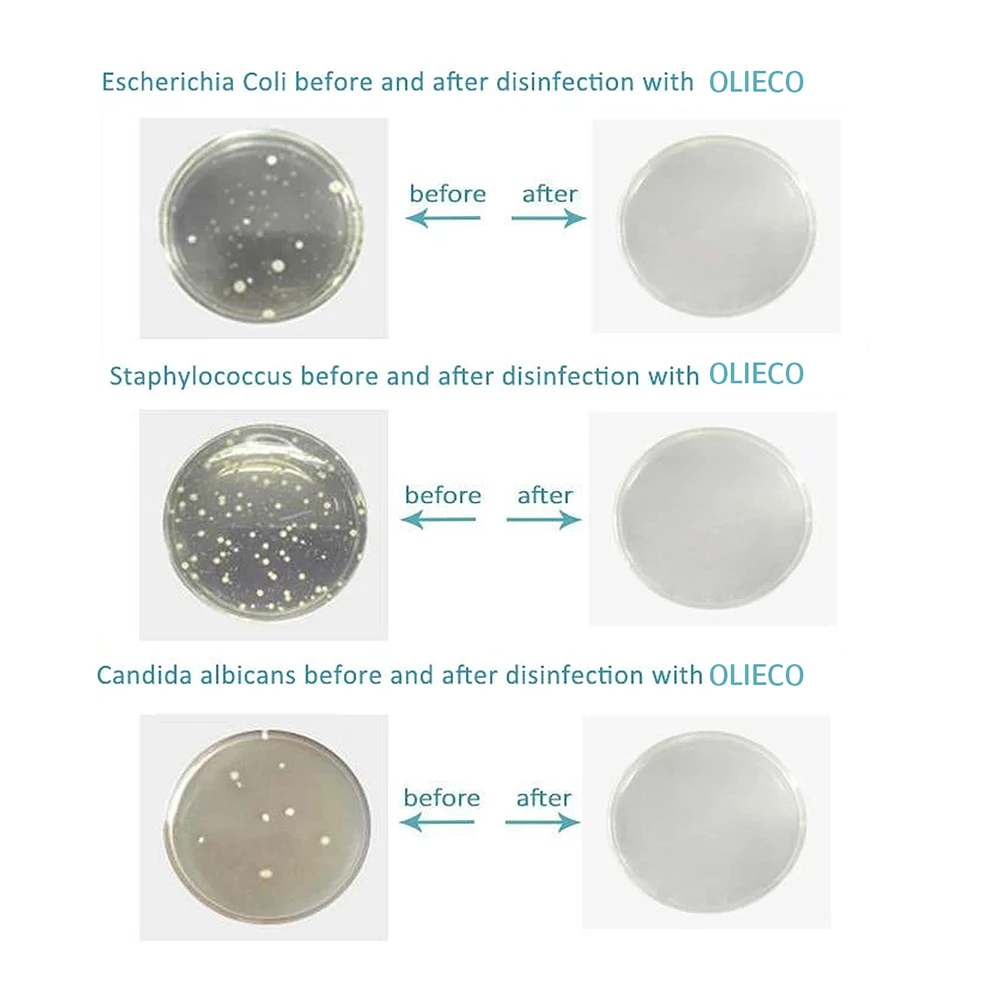
7

Сохраните в закладки:
*История изменения цены! Указанная стоимость возможно, уже изменилось. Проверить текущую цену - >
| Месяц | Минимальная цена | Макс. стоимость | Цена |
|---|---|---|---|
| Mar-22-2026 | 2530.97 руб. | 2657.51 руб. | 2593.5 руб. |
| Feb-22-2026 | 2509.19 руб. | 2634.82 руб. | 2571.5 руб. |
| Jan-22-2026 | 2105.63 руб. | 2210.2 руб. | 2157.5 руб. |
| Dec-22-2025 | 2466.87 руб. | 2589.92 руб. | 2527.5 руб. |
| Nov-22-2025 | 2147.92 руб. | 2254.93 руб. | 2200.5 руб. |
| Oct-22-2025 | 2424.16 руб. | 2545.86 руб. | 2484.5 руб. |
| Sep-22-2025 | 2402.70 руб. | 2522.82 руб. | 2462 руб. |
| Aug-22-2025 | 2381.61 руб. | 2500.71 руб. | 2440.5 руб. |
| Jul-22-2025 | 2360.74 руб. | 2478.60 руб. | 2419 руб. |
Новые товары
Характеристики
Описание товара
OLIECO CPAP очиститель USB Перезаряжаемый озоновый очиститель мини BPAP AutoCPAP стерилизация устройство Портативный освежитель воздуха убивает бактерии

Бренд: OLIECO
Номинальное напряжение: 5 В
Номинальная мощность: <4 Вт
Рабочий диапазон R.H: 5-65%
Диапазон рабочих температур: -5-45 ℃
Выход озона: ~ 20 мг/ч
Литий-ионный аккумулятор: 2000 мАч
Характеристика
1. Сохранение чистоты вашей машины CPAP-это не просто регулярное изменение фильтров. Этот очиститель CPAP предлагает экономичный способ и действительно эффективный способ: он убивает 99.9% бактерий, вирусов, микробов и других патогенов в вашем шланге, масках и CPAP машине и резервуаре.
2. Слегка коснитесь кнопки вкл/выкл на чистом устройстве. Первое касание для режима освежителя воздуха; Второе касание для CPAP машины, трубки и маска режим дезинфекции. Третье касание для выключения устройства.
3. Устройство очистки автоматически отключится после завершения стерилизации
4. Это устройство для очистки можно использовать для освежения воздуха, также просто нажмите кнопку ВКЛ/ВЫКЛ, синий индикатор для «освежителя воздуха» включен, это устройство продувает озоновый газ в течение нескольких минут, чтобы удалить плохие запахи или убить бактерии. Он автоматически отключится, как только он завершит освежение.
5. Простота в использовании-универсальный для 22 мм большинства CPAPs/ Bi-PAP
Внимание:
Не используйте машину CPAP в течение следующих 2 часов после дезинфекции.
Внимание:
1. Когда светодиодный индикатор мигает красным цветом, пожалуйста, заряжайте аккумуляторы вовремя, чтобы избежать использования батареи
Стерилизация не завершена.
2. Держите устройство вдали от воды или огня.
3. Не открывайте пластиковый корпус. Если есть какие-либо вопросы, свяжитесь с дистрибьюторами или
Производитель
Примечание:
В: почему стоит выбрать нас?
О: мы фабрика. Мы поддерживаем OEM для вас. Так же, как товары, которые мы предоставили для других продавцов, которые продают на Aliexpress. Мы поддерживаем дополнительные 2 года послепродажного обслуживания (вам нужно только предоставить доказательства и Получите новый). По сравнению с другими продавцами, вы можете получить больше предложений и услуг, выбрав нас.
Послепродажное обслуживание: Удовлетворение ваших запросов и положительная обратная связь очень важны для нас. Пожалуйста, оставьте5 звездПоложительные отзывы, если вы удовлетворены нашим обслуживанием и товаром. Мы предложим скидку в вашем следующем заказе. Если у вас есть какие-либо проблемы с нашим товаром и обслуживанием, пожалуйста, не стесняйтесь связаться с нами онлайн или по электронной почте, по телефону hellipWe постараемся сделать все возможное, чтобы Вы остались довольны. Политика Возврата Мы вернем вам деньги, если вы вернете товар в течение 15 дней после получения товара без причины. Пожалуйста, сделайте товар в их первоначальном состоянии. Спасибо!

Мне понравился дизайн, нечто похожее недавно видела в бутике. Но там босоножки стоили нереально, а на эти весьма посильная цена.... Читать отзыв полностью...
Тщательно продуманный дизайн и отличное качество звука этих мини-наушников ставит их в один ряд с более крупными моделями...Впечатля юще мощное... Читать отзыв полностью...
Заказывала толстовку для сына. Если честно качество прям удивило, думала придет хуже. Товаром довольна, толстовка теплая стильная, сыну понравилась. С... Читать отзыв полностью...
Пару слов хочу сказать о этих монетах, потому как выписала их в подарок племяннику, он уже много лет собирает их.... Читать отзыв полностью...
Шикарное платье, давно искала именно такое. Выполнено в винтажном стиле, и от него прямо веет духом тех лет. В нем... Читать отзыв полностью...
Давно подыскивала сандалии с такими завязками, чтобы они заплетались выше стопы. В этих на первый взгляд, понравилось все - неброский,... Читать отзыв полностью...
Последние несколько лет часто пользуюсь услугами этой компании, частенько делаю заказы, для дома, для детей и для себя любимой, и... Читать отзыв полностью...